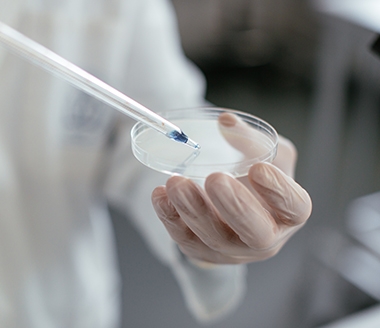

출처 : SK바이오팜.
SK바이오팜은 SK㈜ C&C의 AI 서비스 에이브릴에 기반한 ‘약물설계 플랫폼’ 개발을 완료했다고 15일 밝혔다.
SK바이오팜의 AI 약물설계 플랫폼 기술은 AI모델(약물특성예측/약물설계), 화합물 데이터 보관소, AI 모델 보관소로 구성된다.
AI 모델은 SK㈜ C&C의 머신러닝과 딥러닝 기법을 통해 개발됐다. AI가 화합물의 흡수, 분포 대사, 배설, 독성 등 특성을 파악해 약물작용을 예측한다. 이를 통해 새로운 약물설계를 제안한다.
화합물 데이터 보관소는 화합물의 실험 정보 및 특허 정보 등을 수집해 연구원들이 활용할 수 있게 가공한다. 여기서 쌓인 데이터는 AI모델을 더욱 고도화한다.
맹철영 SK바이오팜 디지털 헬스케어 TF팀 상무는 “유망한 신약 후보물질 발굴 프로세스를 가속화하여 시간과 비용을 획기적으로 단축시킬 수 있을 것으로 기대한다”고 밝혔다.
한편 SK바이오팜과 SK㈜ C&C는 국내 제약 산업의 발전을 위해 이번 플랫폼을 공유 인프라로 발전시키는 방안을 검토 중인 것으로 알려졌다.
곽호룡 기자 horr@fntimes.com


















![외국인, 급락장에도 금융주 '신뢰'···우리금융 114만주 이상 '순매수' [금융지주 밸류업 점검]](https://cfnimage.commutil.kr/phpwas/restmb_setimgmake.php?pp=006&w=69&h=45&m=5&simg=2026030319193107019b4a7c6999c121131189150.jpg&nmt=18)








![송파구 '위례아이파크' 45평, 5.6억 오른 24.5억원에 거래 [일일 신고가]](https://cfnimage.commutil.kr/phpwas/restmb_setimgmake.php?pp=006&w=69&h=45&m=5&simg=2025061908193804321e41d7fc6c2183101242202.jpg&nmt=18)
![[그래픽 뉴스] “AI가 소프트웨어를 무너뜨린다? 사스포칼립스의 진실”](https://cfnimage.commutil.kr/phpwas/restmb_setimgmake.php?pp=006&w=298&h=298&m=1&simg=2026030416113601805de68fcbb3512411124362.jpg&nmt=18)
![[그래픽 뉴스] “돈로주의 & 먼로주의: 미국 외교정책이 경제·안보에 미치는 영향”](https://cfnimage.commutil.kr/phpwas/restmb_setimgmake.php?pp=006&w=298&h=298&m=1&simg=202602261105472649de68fcbb3512411124362_0.jpg&nmt=18)
![[그래픽 뉴스] 워킹맘이 바꾼 금융생활](https://cfnimage.commutil.kr/phpwas/restmb_setimgmake.php?pp=006&w=298&h=298&m=1&simg=202602021638156443de68fcbb3512411124362_0.jpg&nmt=18)
![[그래픽 뉴스] 매파·비둘기부터 올빼미·오리까지, 통화정책 성향 읽는 법](https://cfnimage.commutil.kr/phpwas/restmb_setimgmake.php?pp=006&w=298&h=298&m=1&simg=2026022714105702425de68fcbb3512411124362.jpg&nmt=18)
![[그래픽 뉴스] 하이퍼 인플레이션, 왜 월급이 종잇조각이 될까?](https://cfnimage.commutil.kr/phpwas/restmb_setimgmake.php?pp=006&w=298&h=298&m=1&simg=202601141153149784de68fcbb3512411124362_0.jpg&nmt=18)
![[AD] 현대차, 글로벌 안전평가 최고등급 달성 기념 EV 특별 프로모션](https://cfnimage.commutil.kr/phpwas/restmb_setimgmake.php?pp=006&w=89&h=45&m=1&simg=20260106160647050337492587736121125197123.jpg&nmt=18)
![[AD] 현대차 ‘모베드’, CES 2026 로보틱스 부문 최고혁신상 수상](https://cfnimage.commutil.kr/phpwas/restmb_setimgmake.php?pp=006&w=89&h=45&m=1&simg=20260105103413003717492587736121125197123.jpg&nmt=18)
![[AD] 기아 ‘PV5’, 최대 적재중량 1회 충전 693km 주행 기네스 신기록](https://cfnimage.commutil.kr/phpwas/restmb_setimgmake.php?pp=006&w=89&h=45&m=1&simg=20251105115215067287492587736121125197123.jpg&nmt=18)
![[카드뉴스] KT&G, 제조 부문 명장 선발, 기술 리더 중심 본원적 경쟁력 강화](https://cfnimage.commutil.kr/phpwas/restmb_setimgmake.php?pp=006&w=89&h=45&m=1&simg=202509241142445913de68fcbb3512411124362_0.png&nmt=18)
![[AD]‘황금연휴에 즐기세요’ 기아, ‘미리 추석 페스타’ 이벤트 실시](https://cfnimage.commutil.kr/phpwas/restmb_setimgmake.php?pp=006&w=89&h=45&m=1&simg=20250903093618029117492587736121166140186.jpg&nmt=18)



